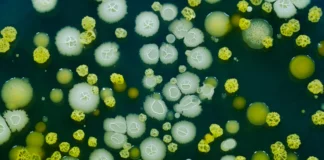
Frontiers | Diagnostic challenges and treatment breakthroughs in Malassezia restricta-induced meningoencephalitis: a real-world analysis of early mNGS applications Frontiers | Diagnostic challenges and treatment breakthroughs in Malassezia restricta-induced meningoencephalitis: a real-world analysis of early mNGS applications

Madrigal’s Surge: Breakthrough in Liver Treatment?
On Thursday, Madrigal Pharmaceuticals Inc. stocks have been trading up by 11.21 percent, amid innovation and analyst upgrades.
Live Update At 14:32:50 EST: On Wednesday,...
Breast cancer breakthrough as new test could revolutionise treatment’
Your support helps us to tell the storyFrom reproductive rights to climate change to Big Tech, The Independent is on the ground when the...
Precision Medicine Breakthroughs: Advancements in Healthcare Technology
ChatGPT said:
Precision medicine leverages genomics, AI, biomarkers, and gene-editing to deliver personalized treatments. Emerging tools like CRISPR, liquid...
Source link
Breakthrough Discovery in Brain Stem Cell Study
A collaborative study conducted by QIMR Berghofer and London’s Francis Crick Institute explored the resting state of brain stem cells.Scientists identified how brain stem...
Frontiers | Diagnostic challenges and treatment breakthroughs in Malassezia restricta-induced meningoencephalitis:...
BackgroundMalassezia restricta is a lipid-dependent yeast species that commonly colonizes human and warm-blooded animal skin as an opportunistic pathogen. Al...
Source link
T-DXd Granted Breakthrough Therapy Designation by FDA in HER2+ Breast Cancer
The median PFS per BICR was 40.7 months in the T-DXd arm vs 26.9 months in the THP arm, for a difference of about...
Science runs on serendipity, but federal cuts could make our luck...
A professor at Cornell University, a Jacksonville native, describes how luck plays a role in scientific advancement — but so does steady funding.
Source link...
FDA Grants Breakthrough Therapy Designation to Frontline T-DXd Plus Pertuzumab in...
The FDA has granted breakthrough therapy designation to fam-trastuzumab deruxtecan-nxki (T-DXd; Enhertu) in combination with pertuzumab for the first-line treatment of adult patients with...